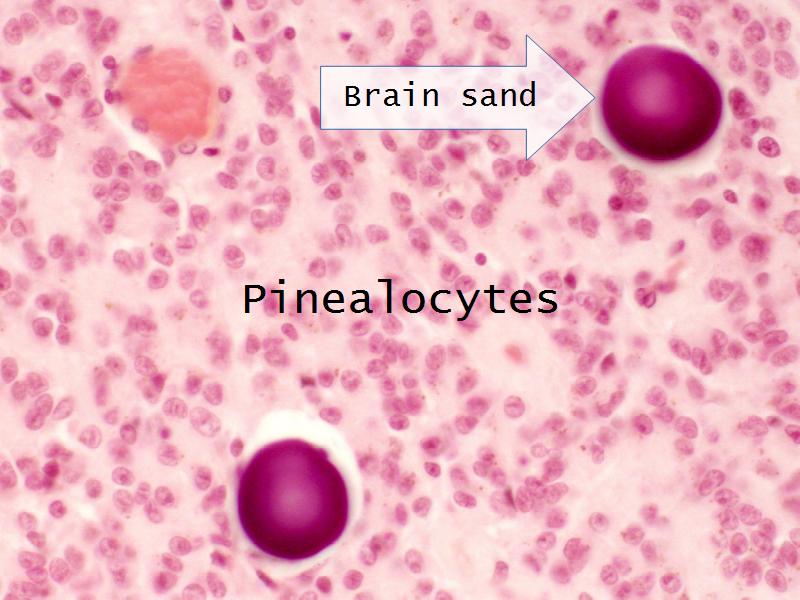

- esc key shows all the slides
- arrows left right advance the slide
- mobile device swipe left right
- slides can go left-right and up-down
- ? gives instant help
- menu bottom left
- Have a pen & paper ready
- Answer every question
- Mark your answer after answering
- Elaborate on each answer
- Add relevant clinical content
- If you have trouble, ask






Meta-learning


Philosophy 1
What is the least amount of work I can do so I can get out of here.Philosophy 2
Today and Now I will do something for my future self.







Community of Truth
What is my answer?What is the correct answer?
I am am wrong, what was my error?
THUS: Find the truth

Name 10 endocrine organs
- Pituitary gland
- Thyroid gland
- Parathyroid glands
- Adrenal glands
- Pancreas
- Kidney
- Testis
- Ovary
- Corpus luteum
- Pineal gland
Question B1 to B4
For each of the following 4 slides
Which gland is arranged as:








Which hormone is secreted by:
- C1: Pineal gland
- C2: Testis
- C3: Pancreas
- C4: Thyroid gland
Which hormone is secreted by:
- C1: Pineal gland = melatonin
- C2: Testis = testosterone
- C3: Pancreas = glucagon, insulin, somatostatin, pancreatic polypeptide
- C4:Thyroid gland = thyroxine, triiodothyronine
Which hormone is secreted by:
- D1: Leydig cells
- D2: Oxyphil cell
- D3: Follicular cell
- D4: Somatotropes
Which hormone is secreted by:
- D1: Leydig cells = testosterone
- D2: Oxyphil cell = none
- D3: Follicular cell = thyroxine, triiodothyronine
- D4: Somatotropes = growth hormone
Which cell synthesize:
- E1: ACTH
- E2: Oxytocin
- E3: Vasopressin
- E4: PTH
Which cell synthesize:
- E1: ACTH = basophils in the pituitary gland
- E2: Oxytocin = neurons in the hypothalamus
- E3: Vasopressin = neurons in the hypothalamus
- E4: PTH = Chief cells in the parathyroid
In which glands are these cells located:
- F1: Chromaffin cells
- F2: Pituicytes
- F3: Granulosa cell
- F4: Alpha cells
In which glands are these cells located:
- F1: Chromaffin cells = adrenal medulla
- F2: Pituicytes = pars nervosa of the posterior pituitary
- F3: Granulosa cell = ovarian follicle
- F4: Alpha cells = pancreas
Give two anatomical relations for each of the following:
- G1: Thyroid
- G2: Parathyroid
- G3: Adrenal glands
- G4: Pineal gland
Give two anatomical relations for each of the following:
- G1: Thyroid = anterior neck, below the laryngeal prominence, in front of trachea
- G2: Parathyroid = anterior neck behind the thyroid gland
- G3: Adrenal glands = superior poles of the kidneys
- G4: Pineal gland = in the midline of the brain behind the third ventricle
Question H
Do you have a life list?
Yes | No
Why not?
Start one!
Question H
MBChB
Class of ?

Slides for review
- Slide 52: Pituitary gland
- Slide 55: Thyroid gland
- Slide 54: Parathyroid glands
- Slide 56: Adrenal glands
- Slide 50: Pancreas
- Slide 76: Kidney
- Slide 84: Testis
- Slide 89/106: Ovary
- Slide 91: Corpus luteum
- Slide 34: Pineal gland


Pituitary gland
How does the pituitary and hypothalamus communicate?2 ways












Thyroid gland
Four elements making up the thyroid
Thyroid gland
- Follicle
- Follicular epithelium
- Parafollicular cells
- Colloid
- Identify them on the next slide












Chief cells = majority
Oxyphil (acidophil) = single/groups

Adrenal glands
Capsule
Cortex - how many zones?
Medulla
Hormones of each?




































Pineal Gland

The End
Save Document
- Click the link above
- Print to PDF
Works best using Google Chrome
Others Browser YMMV